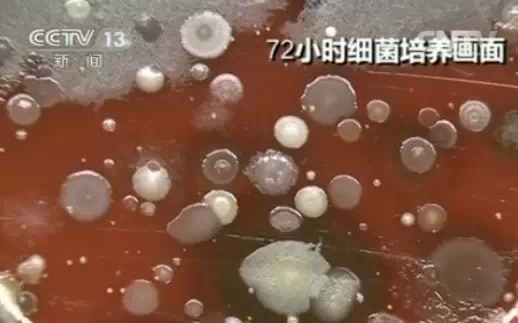
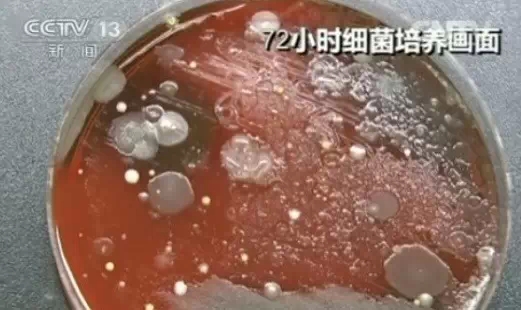
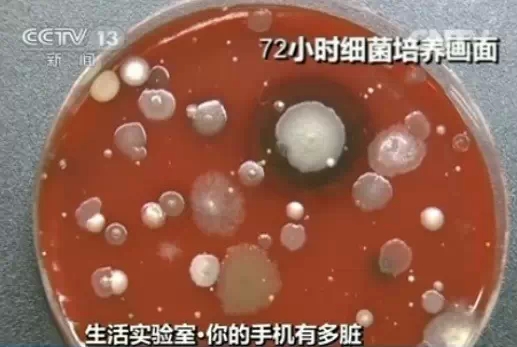

实验检测手机表面细菌脏过马桶18倍
手机已经成为我们生活中不可缺少的必需品,但手机表面的卫生情况却一直被很多人忽视。近日,网络上一组手机表面细菌脏过马桶18倍的照片让不少网友惊呼每天抱着马桶吃饭睡觉。手机细菌的数量真的很多?央视新闻生活实验室通过实验,看看手机到底有多脏。

实验检测手机有多脏
日前,记者与医院的工作人员将几位被访者的手机进行了表面细菌采样。
工作人员将包括采集到的包括出租车司机的小屏幕手机、小朋友不停在玩着手机游戏的苹果手机等,不同的几部手机提取样本分别与培养皿进行涂抹接触。在此之后,根据检验流程工作人员将所有样本放置于恒温恒湿的孵箱之内静待观察。

经过了第一个24小时,大部分的培养皿中都长出了小如针尖,大如小米大小的菌落,但一部经常被擦拭的手机培养皿中与之前并无区别,看似非常干净。但在第二个24小时过后,之前看似干净的培养皿中也未能幸免,同样长出了很多肉眼可见的菌落,而之前针尖大小的菌落变成了米粒大小。
在经过了第三个24小时,我们发现送检的每一个培养皿中都长出了不同颜色以及大小清晰的菌落,最大的有硬币大小。

△这是一位经常用酒精擦拭手机的出租汽车司机的手机细菌情况。
△这是一位在手机屏幕脏得看不下去的时候会用手擦拭的女士的手机细菌情况。
△这个是一位小朋友父亲手机的细菌情况。
△这个是一位称手机脏得像便后不洗手一样的大娘的手机细菌情况。
ATM机、冲水马桶都比手机干净?
为了与手机表面的细菌情况有一个直观的对比,在采样之初记者与工作人员也同时采集了ATM机、电梯按键、冲水马桶表面的细菌。经过了同样的采集方式、同样的检验方法以及同样的培养时间之后会是什么结果?
经过对比后记者发现,几乎是所有的手机细菌样本的污染情况都要比ATM机的被污染情况要严重。不仅如此,电梯按键、冲水马桶按键的被污染情况也都优于送检手机。

手机细菌不可怕但要小心致病菌
专家介绍,虽然我们通过实验看到手机表面的污染情况非常严重,但是所谓脏与不脏,严格上来讲主要是看那些对于人体有害的致病菌,对于普通的细菌我们也不用过于紧张。
虽然此次培养的手机表面细菌样本中未发现明显的致病菌,但手机作为我们日常生活中重要的细菌载体,接触到致病菌的几率也是很高的。
空军总医院感染控制科主任曹晋桂表示:“有专家做过实验,测试100个护士手机,有24个存在病原菌。一个密切接触公共环境的人,手机存在病原菌污染的可能性就高。手传给手机,手机又通过打电话,与鼻子、皮肤、耳朵传给打电话的人。很多病原菌会携带7天左右,特殊的还能更长到21天左右。”
专家表示,一个身体健康的成年人有着自身强大的免疫系统,对细菌甚至是一些致病菌都有着很强的抵抗力。但对于老人和孩子而言,对于手机的清洁和卫生一定要格外注意。
消毒湿巾擦拭手机屏幕效果好
曹晋桂表示,正常的消毒清理对手机表面的清洁可以起到很好的效果。但要注意的是手机的清洁要与手一起进行才能避免细菌的交叉传递。曹晋桂说:“湿巾、酒精、紫外线灯都是有效的,可以用带有清洁剂的湿巾清洁手机。”
本文转自:温州新闻网 66wz.com
相关新闻
为你推荐
-

市委工作务虚会召开
要闻12-12
-

温州市第十四次妇女代表大会开幕
要闻12-12
-

11月份,温州CPI同比下降0.3%
经济12-12
-

温州理工学院附属三所学校正式揭牌
科教文体12-12
-

北麂山灯塔实行值守志愿服务满十年 守出“心灵的宁静”
社会12-12
-

吃的玩的赏的陆续开张 洞头东沙不夜港旅游业态再“扩圈”
社会12-12
-

全景沉浸式探索戏曲观演新样式 温越版《封神》邀你“入局”
科教文体12-12
-

永嘉农产品“出海”拓市场
经济12-12
-

十几岁孩子腰椎间盘突出 “腰不好”越来越年轻化
社会12-12
-

郑思维迎来国际赛场“最后一舞”
科教文体12-12


